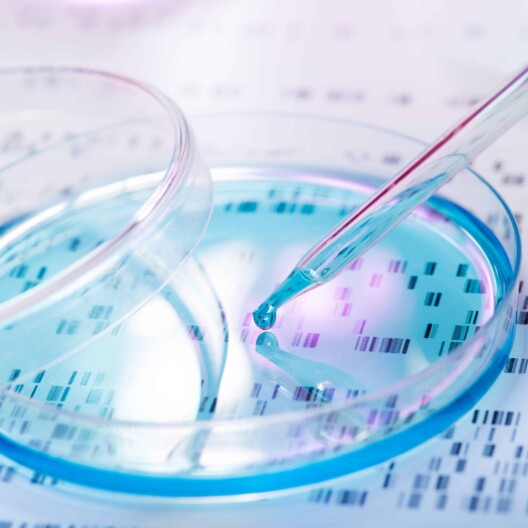

Personalized Medicine Bulletin
With the myriad IP, business, regulatory, IT, privacy, and research developments unfolding and impacting the development of the personalized medicine industry, it’s critical that to stay informed. Personalized Medicine Bulletin is an online resource covering the legal, ethical, and business issues that impact the evolution of personalized medicine.





